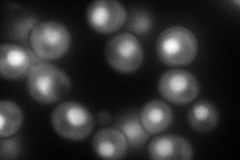
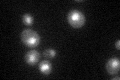

View description
Essential NTPase required for small ribosome subunit synthesis, mediates processing of the 20S pre-rRNA at site D in the cytoplasm but associates only transiently with 43S preribosomes via Rps14p, may be the endonuclease for site D
Localization:
Intensity:
Fold change:
Significance:
-
C’ GFP library in SD

nucleus54.55 -
N' NOP1pr-GFP in SD
cytosol,nucleus179.936 -
N' TEF2pr-mCherry in SD

cytosol,nucleus4.42501 -
N' NATIVEpr-GFP in SD

below threshold52.043 -
N' TEF2pr-VC and Cyto-VN in SD

nucleus67.7845 -
C’ GFP library in SD+DTT

nucleus53.010.97No -
C’ GFP library in SD+H2O2

nucleus52.430.96No -
C’ GFP library in Starvation Media
nucleus52.940.97No -
C’ GFP library on the background of Pup2-DaMP

nucleus -
C’ GFP library on the background of CCT mutant

nucleus66.9841.2277No
